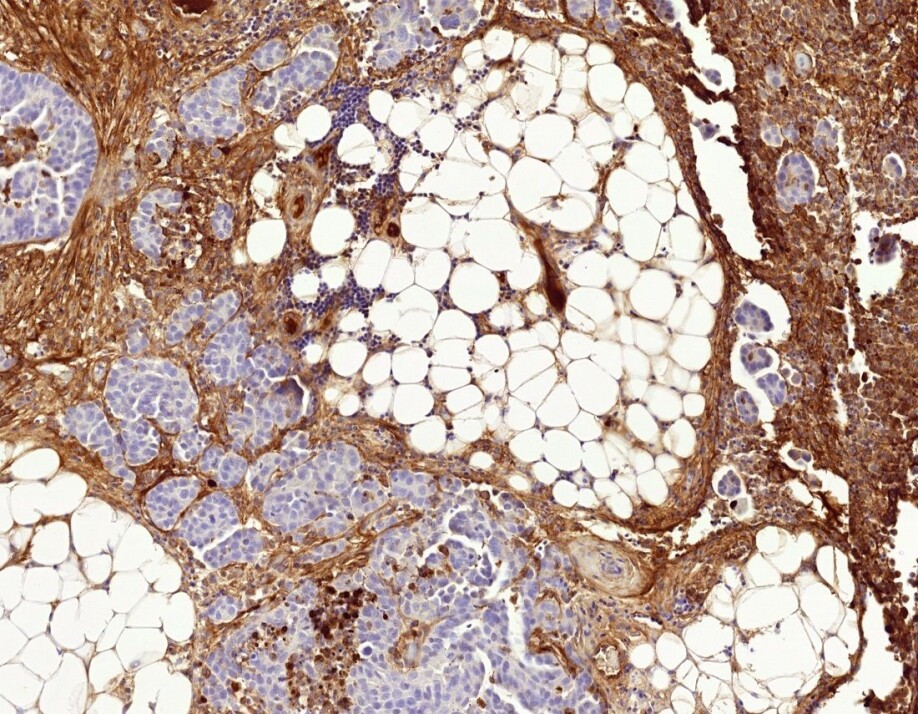

THIS ARTICLE/PRESS RELEASE IS PAID FOR AND PRESENTED BY NTNU Norwegian University of Science and Technology - read more

Cytotoxic drugs can increase cancer cell resistance
The cytotoxic drugs used in chemotherapy can themselves contribute to the cancer cells developing resistance to treatment.
Cancer cells sometimes develop resistance to the cytotoxic drugs used in chemotherapy. Figuring out why the treatment isn’t working and why it may even defeat its own purpose is therefore important to understand.
“We haven’t understood very much about how this resistance to chemotherapy develops and even less about how the microenvironment in cancer can affect the process,” says Kaisa Lehti, a professor at NTNU’s Department of Biomedical Laboratory Science.
Lehti has led the work to understand more about how cancerous tissues develop resistance to a particular form of chemotherapy. The University of Helsinki, Karolinska Institutet and NTNU have collaborated on the research. The results have now been published in the well-respected Nature Communications journal.
Standard treatment may fail
Ovarian cancer affects about 500 Norwegian women each year. If the cancer is detected early, almost all patients survive the first five years. But if it is discovered later, the chances of survival are much worse. Finding effective treatment is therefore very important.
One of the standard treatments for ovarian cancer is called platinum chemotherapy. The cytotoxins are so named because they contain platinum compounds. They are often effective in treating various cancers.
Unfortunately, cancer cells often develop resistance to this particular platinum chemotherapy treatment. The solution lies in how the cytotoxin itself can change the cancer cells and their environment.
Cytotoxin changes cancer cells and environment
Lehti sums up the process. “The cytotoxin can change the way the cancer cells send and perceive signals and can modify the microenvironment around the cells.”
This change allows the cancer cells to withstand the damage caused by the cytotoxin – and can thus survive the chemotherapeutic attack. The researchers have found this key to the puzzle in a layer of tissue that often surrounds cancer cells.
“A fibrotic network of proteins, known as the extracellular matrix or ECM, surrounds the cancer cells, particularly the most aggressive ones,” says Lehti.
Develops resistance
Fibrotic tissue is formed when the body tries to repair an injury. The fibrotic tissue, with the ECM network around the cancer cells, is mainly produced by normal connective tissue cells. But the cancer cells and connective tissue cells in the network can alter this tissue themselves.
“Previously, we haven’t known how the communication between the cancer cells and the extracellular matrix is affected by, or even itself influences, the development of cancer and its response to chemotherapy,” says Lehti.
But we know more about that now. Chemical and mechanical signals in the surrounding ECM tissue are already known to help cancer develop its ability to spread and to resist treatment.
“Certain signals from the ECM can critically change the cancer cells’ resistance to platinum-based cytotoxic drugs,” explains Professor Kaisa Lehti.
The cytotoxin can thus help to change both the microenvironment around the cancer cells and the ability of the cancer cells to receive and sense signals in the environment that help them to resist the cytotoxin. This can cause the cytotoxin to eventually not work.
The increased knowledge about these mechanisms is helpful when choosing treatments for people with cancer.
Reference:
Elina A. Pietilä et.al.: Co-evolution of matrisome and adaptive adhesion dynamics drives ovarian cancer chemoresistance. Nat Commun, 2021.
———
Read the Norwegian version of this article at forskning.no
See more content from NTNU:
-
Common drugs can help viruses spread
-
Valuable possessions were not returned to Norwegian Jews after the war
-
How can towns be protected from lava flows?
-
Remarkable results in treating panic disorder: Treatment has a strong long-term effect
-
Physically active adolescents are less likely to be depressed
-
High mercury levels found in birds on Svalbard